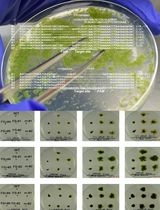
CRISPR/Cas9-Induced Targeted Mutagenesis of the Moss <em>Physcomitrium patens</em> by Particle Bombardment-Mediated Transformation

Published: Vol 15, Iss 10, May 20, 2025 DOI: 10.21769/BioProtoc.5319 Views: 1798
Reviewed by: Anonymous reviewer(s)

Protocol Collections
Comprehensive collections of detailed, peer-reviewed protocols focusing on specific topics
Related protocols

Transgene-free Genome Editing in Grapevine
Edoardo Bertini [...] Sara Zenoni
Feb 20, 2025 2496 Views

An Effective and Safe Maize Seed Chipping Protocol Using Clipping Pliers With Applications in Small-Scale Genotyping and Marker-Assisted Breeding
Brian Zebosi [...] Erik Vollbrecht
Feb 5, 2025 1847 Views
CRISPR/Cas9-Induced Targeted Mutagenesis of the Moss Physcomitrium patens by Particle Bombardment-Mediated Transformation
So Takenaka [...] Setsuyuki Aoki
Sep 20, 2025 1005 Views
Abstract
The identification of chemical compounds that affect intracellular processes has greatly contributed to the understanding of developmental regulation in plants. In this protocol, we describe a method for identifying chemical compounds that affect cold-regulated gene expression in Arabidopsis thaliana. Specifically, we generated Arabidopsis plants harboring a COLD-REGULATED 15A (COR15A) promoter::luciferase (COR15Apro::LUC) construct and grew them in a submerged liquid culture. Using a single true leaf excised from COR15Apro::LUC plants and 96-well culture plates, we performed high-throughput screening of chemical compounds that inhibit cold-induction of COR15Apro::LUC. Luciferase activity was detected using a microplate reader and a chemiluminescence imaging device. This protocol can be easily used for the identification of chemical compounds that regulate other processes, being versatile with respect to equipment.
Key features
• High-throughput screening of chemical compounds that affect cold-regulated gene expression is possible using a single leaf excised from Arabidopsis grown in a submerged culture.
• Screening is based on luciferase activity derived from an excised single leaf.
• Direct measurement of luciferase activity is possible using a microplate reader and a chemiluminescence imaging device.
• This protocol can be easily used for the identification of chemical compounds that regulate other processes.
Keywords: Arabidopsis thalianaGraphical overview
Graphical summary of a screening method for identifying compounds that inhibit low-temperature induction of COR15Apro::LUC
Background
The identification of chemical compounds that affect intracellular processes has greatly contributed to the understanding of developmental regulation in plants. However, high-throughput chemical screening of plant tissues faces some challenges due to the nature of plants. First, most chemical screening uses germinating seedlings (∼1-week-old seedlings at best) or plant cell cultures [1–6] and not mature tissues. Chemical screening using mature plant tissues of Arabidopsis, with a lifetime of more than two months, would be of great benefit to further understand plant growth and development. Second, leaf tissues are surrounded by cuticle layers, and this makes it difficult for compounds to enter the plant cell. Therefore, the establishment of a screening system using mature plant tissues would allow a better understanding of signaling pathways that regulate plant growth and development during the mature stage.
In this study, we describe a high-throughput screening method using single leaves of mature plants to identify small molecules that affect cold-regulated gene expression [7]. In this protocol, we used transgenic Arabidopsis thaliana harboring the COLD-REGULATED 15A (COR15A) promoter::luciferase (COR15Apro::LUC) construct as a model. COR15A was originally identified as a cold-induced gene, but its expression was induced more than 100 times by abscisic acid (ABA) treatment [8]. Moreover, cycloheximide (CHX) has been shown to inhibit cold acclimation in multiple plant species [9,10]. The characteristics of these two compounds made it easy to set up this assay system.
Although we only investigated low-temperature response in this experiment, the protocol can be applied to other plant responses to endogenous (e.g., phytohormones) and environmental cues. The protocol is compatible with imaging devices and microplate readers. The protocol enables the identification of new compounds that control plant growth and development and provides new insights into the molecular mechanisms underlying plant growth and development.
Materials and reagents
Biological materials
1. Arabidopsis thaliana harboring COR15Apro::LUC construct
See General note 1.
Reagents
1. Murashige and Skoog plant salt mixture (MS salt) (Wako, catalog number: 392-00591)
2. Sucrose (Wako, catalog number: 196-00015)
3. 2-Morpholinoethanesulfonic acid monohydrate (MES) (Dojindo, catalog number: 343-01621)
4. D-Luciferin, potassium salt (GOLDBIO, catalog number: LUCK-1G)
5. Cycloheximide (Wako, catalog number: 037-20991)
6. TritonTM X-100 (ICN Biomedicals Inc., catalog number: 807426)
7. Dimethyl sulfoxide (DMSO) (Wako, catalog number: 043-07216)
8. Ethanol (Wako, catalog number: 057-00456)
9. Chlorine-based bleach (e.g., KAO Kitchen Haiter)
10. Autoclaved dH2O
Solutions
1. 0.5× MS liquid medium (see Recipes)
2. 50 mM D-Luciferin (see Recipes)
3. 2 mg/mL cycloheximide (see Recipes)
4. 20% (w/v) Triton X-100 (see Recipes)
5. MS-Luciferin solution (see Recipes)
6. 70% (v/v) ethanol (see Recipes)
7. Seed sterilization solution (see Recipes)
8. 0.1% agar solution (see Recipes)
Recipes
1. 0.5× MS liquid medium
| Reagent | Final concentration | Quantity or Volume |
|---|---|---|
| MS salt | 0.5× | 0.23 g |
| MES | 0.5 g/L | 0.05 g |
| Sucrose | 1% | 1 g |
| dH2O | 100 mL |
This recipe is for two flasks. Adjust the volume to the amount you need. In general, divide the 100 mL of 0.5× MS liquid medium into two flasks (50 mL each) and then autoclave the flasks wrapped with aluminum foil. Autoclaved medium can be stored for at least two weeks at room temperature and under sterile conditions.
2. 50 mM luciferin
| Reagent | Final concentration | Quantity or Volume |
|---|---|---|
| D-Luciferin, potassium salt | 50 mM | 0.2 g |
| dH2O | 12.6 mL |
Smaller amounts can be prepared depending on the objective. Luciferin (50 mM) can be aliquoted into 1.5 mL tubes and stored at -80 °C.
3. 2 mg/mL cycloheximide
| Reagent | Final concentration | Quantity or Volume |
|---|---|---|
| Cycloheximide | 2 mg/mL | 2.4 mg |
| DMSO | 1.2 mL |
In this study, 2 mg/mL of cycloheximide was used because the concentration of the chemical compounds in our library was 2 mg/mL [7]. This concentration can be modified depending on the assay.
4. 20% (w/v) Triton X-100
| Reagent | Final concentration | Quantity or Volume |
|---|---|---|
| TritonTM X-100 | 20% (w/v) | 20 g |
| dH2O | 100 mL |
This recipe is for non-sterile conditions. You may use a commercially available sterile-filtered Triton X-100 if necessary.
5. MS-Luciferin solution (for 100 wells)
| Reagent | Final concentration | Quantity or Volume |
|---|---|---|
| 0.5× MS liquid medium | 0.5× | 20 mL |
| 50 mM luciferin | 0.5 mM | 200 μL |
| 0.1% (w/v) Triton X-100 | 0.001% | 200 μL |
Dilute 20% (w/v) Triton X-100 in dH2O.
6. 70% (v/v) ethanol
| Reagent | Final concentration | Quantity or Volume |
|---|---|---|
| Ethanol | 70% (v/v) | 7 mL |
| dH2O | Up to 10 mL |
7. Seed sterilization solution
| Reagent | Final concentration | Quantity or Volume |
|---|---|---|
| Chlorine-based bleach | 30% | 3 mL |
| 20% (w/v) Triton X-100 | 0.02% | 10 μL |
| dH2O | Up to 10 mL |
8. 0.1% agar solution
Add 0.1 g of agar for plant culture in 100 mL of dH2O and autoclave.
Laboratory supplies
1. 96-well PCR plate (e.g., BIO-BIK, catalog number: 3425-00)
2. 96-well culture plate (e.g., Nunc 96-well flat bottom, catalog number: 136101)
3. Stainless steel scissors
4. Stainless steel tweezers
5. Kimwipe and Kimtowel (Nippon Paper Cresia); these should be autoclaved if the experiments require sterile conditions
6. 100 mL flask (e.g., Iwaki, catalog number: 4980FK100)
7. Microtube 1.5 mL (e.g., SSIbio, catalog number: 1210-00)
8. 15 mL and 50 mL conical tubes (e.g., Falcon)
Equipment
1. Varioskan Flash microplate reader (Thermo Fisher Scientific)
2. LuminoGraph I imaging device (ATTO Co. Ltd., Japan) (Optional)
3. Growth chamber (e.g., Nippon Medical & Chemical Instruments Co., Ltd.)
4. Multichannel pipette
Software and datasets
1. SkanIt Software 2.4.3 (operating software for Varioskan Flash microplate reader)
2. ImageSaver 6 (operating software for LuminoGraph I chemiluminescence imaging device) (Optional)
3. CS Analyzer image analysis software (attached to LuminoGraph I) (Optional)
Procedure
A. Submerged culture of Arabidopsis plants in MS liquid medium
1. Sterilize Arabidopsis seeds. Place Arabidopsis seeds into a 1.5 mL tube, add 1 mL of 70% ethanol to the tube, and mix by rotation for 5 min. Remove 70% ethanol using a pipette, add 1 mL of seed sterilization solution (see Recipes) to the tube, and mix by rotation for 10 min. Remove the sterilization solution using a pipette and perform five washing cycles with autoclaved dH2O. Suspend seeds in 0.1% agar solution.
2. Place 20–25 seeds into each 100 mL flask containing 50 mL of 0.5× MS liquid medium using a pipette.
3. Keep the flask at 4 °C for 2–3 days to synchronize seed germination.
4. Incubate the flask at 22 °C under continuous light (60–80 μE) in a growth chamber to grow plants in a submerged culture. Generally, it takes 11–12 days to obtain plants suitable for our assay (Figure 1).

B. Preparation of compounds in a 96-well PCR plate
1. Dispense 2 μL of chemical compounds of your interest into each well of 96-well PCR plates. In this study, we used compounds dissolved in DMSO. This preparation can be performed on the day before the assay. The plate can be stored at -25 °C (or -80 °C for long-term storage).
Critical: Negative and positive controls should be included in the plate. Use four wells each for DMSO (negative control) and cycloheximide (positive control). Use column number 12 for the controls. You may increase the number of controls if necessary. See General note 2.
C. Preparation of a 96-well culture plate containing MS liquid medium and luciferin
1. Dispense 204 µL of MS-Luciferin solution (see Recipes) into each well of a 96-well culture plate.
D. Excise a single leaf from cultured Arabidopsis plants and place it into a culture plate
1. Excise true leaves from cultured Arabidopsis thaliana and place a single leaf into each well. In general, transfer the cultured Arabidopsis from a flask to a plastic container (Figure 2). After removing excess MS medium using the Kimwipe, cut true leaves and put them into each well using tweezers. Alternatively, you may first cut the leaves in a plastic container filled with MS medium and then remove the excess MS later. This procedure can be performed under sterile conditions if necessary. In this case, the plastic container and Kimwipe must be autoclaved before use. See General note 3.

E. Incubation of each single leaf with compounds
1. Take 2 μL of each compound from a 96-well PCR plate and put it into a 96-well culture plate (Figure 3). Use a multichannel pipette to reduce the operation time.
2. Shake the culture plate briefly.
3. Incubate the plate at 4 °C under continuous light for 24 h (Figure 3). In this case, induce COR15A pro::LUC strongly at low temperatures after 24 h. Incubation conditions can be altered depending on the objective.

F. Measurement of luciferase activity using Varioskan Flash microplate reader
1. After incubation for an appropriate time, transfer the plates to a microplate reader.
2. Record chemiluminescence:
a. Start SkanIt software.
b. Measure luciferase activity using luminometric measurement mode.
3. Once the measurement is performed, export the data as a text file (.txt).
G. Measurement of luciferase activity using LuminoGraph I
Optional. See General note 4.
1. After incubation for an appropriate time, place the plate into a LuminoGraph I (or another chemiluminescence imaging device).
2. Capture chemiluminescence:
a. Start ImageSaver 6.
b. Use Sum (constant-time) mode with high sensitivity (8×8) to capture the images. We usually use the sum of the 1-min exposure.
3. Quantify luminescence in each well using CS Analyzer software (or other appropriate software).
See General notes 5 and 6.
Data analysis
Export the raw values (luminescence units) to Microsoft Excel and open the data. Calculate the average luminescence units of the positive (CHX) and negative (DMSO) controls and then express the relative luminescence of each well as a percentage of the negative control (Figure 4). Screen for compounds that caused at least 90% inhibition of luciferase activity after low-temperature treatment in the first screening (Figure 4). You can combine percentile data of multiple plates into a single figure, as we did in our previous study [7].


Validation of protocol
This protocol or part of it has been used and validated in the following research article:
Kitawaki et al. [7] Chemical screening approach using single leaves identifies compounds that affect cold signaling in Arabidopsis. Plant Physiol.
General notes and troubleshooting
1. Choice of biological materials: We used Arabidopsis thaliana harboring COR15Apro::LUC construct to screen chemical compounds that affect cold-regulated gene expression. However, this material can be changed, depending on the objective.
2. Sample size of control: Positive and negative controls are the most important factors that affect data interpretation. Four positive and negative controls were added to each plate. However, owing to the nature of the assay, there was considerable variation in the luciferase activity between the leaves. Therefore, you may increase the number of control samples depending on the variation in the assay.
3. Effects of leaf size on luciferase activity: We previously reported the effect of leaf size on the luciferase activity of COR15Apro::LUC [7]. We confirmed that the differences in size did not significantly affect the low-temperature responses.
4. Choice of measurement device: If available in your institution, a microplate reader should be your first choice for detecting luciferase activity. It directly quantifies the luciferase activity, which makes data processing easier. Alternatively, chemiluminescence imaging devices can be used for this purpose. However, in this case, the signal intensities need to be quantified using image analysis software.
5. Measurement of luciferase activity: If the luciferase activity is undetectable or too low, check the sensitivity of the device (e.g., use a high-sensitivity mode). The detection time may also be increased.
6. Replication of test samples: In a previous study [7], we used two independent leaves for each compound and calculated the average to evaluate the effects of each compound. If the volume of available compounds is limited, one leaf may be used for each compound during the first screening. However, we recommend increasing the number of leaves during the second screening period.
Acknowledgments
We thank Ms. Saori Hamada (University of Miyazaki, Japan) for her technical assistance. This study was supported by a Grant-in-Aid for Scientific Research from the Ministry of Education, Culture, Sports, Science, and Technology of Japan (20H02917 and 25K01953 to Y.I.I., 24K01683 and 24K21843 to T.I.) and a Sasakawa Scientific Research Grant from the Japan Science Society (to K.K. and R.M.).
Competing interests
Authors declare that they have no competing interests.
References
Article Information
Publication history
Received: Feb 27, 2025
Accepted: Apr 24, 2025
Available online: May 11, 2025
Published: May 20, 2025
Copyright
© 2025 The Author(s); This is an open access article under the CC BY-NC license (https://creativecommons.org/licenses/by-nc/4.0/).
How to cite
Readers should cite both the Bio-protocol article and the original research article where this protocol was used:
Category
Plant Science > Plant physiology
Plant Science > Plant molecular biology > Genetic analysis
Do you have any questions about this protocol?
Post your question to gather feedback from the community. We will also invite the authors of this article to respond.
Share
Bluesky
X
Copy link

